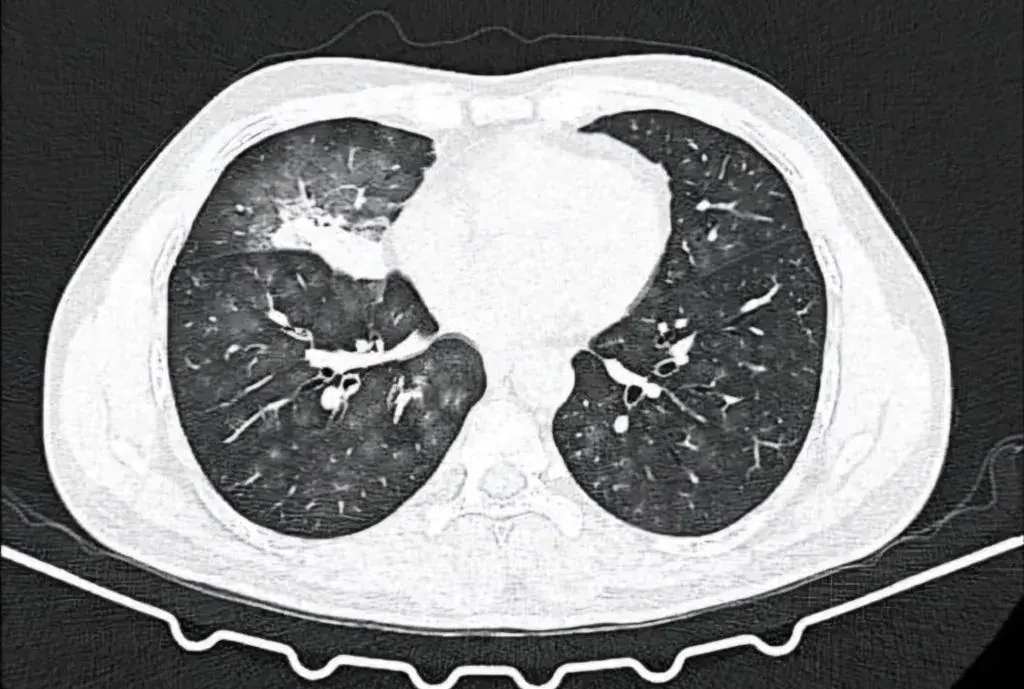

Showing 15 of 15 case studies

11-Year-Old Male Child with Highest Documented Levels of Serum Bilirubin 65 mg/dl
January 2024
CME INDIA Case Study: 11-Year-Old Male Child with Highest Documented Levels of Serum Bilirubin 65 mg/dl...

12-Year-Girl With Obesity: Was The Diagnosis Missed?
January 2024
CME INDIA Case Study: 12-Year-Girl With Obesity: Was The Diagnosis Missed?...

15-Year-Old-Male Found Unconscious in Bathroom
January 2024
CME INDIA Case Study: 15-Year-Old-Male Found Unconscious in Bathroom...

22-year-old Male With a Sudden Onset of Fever and Petechial Skin Lesion
January 2024
CME INDIA Case Study: 22-year-old Male With a Sudden Onset of Fever and Petechial Skin Lesion...

A Curious Case of Hemoptysis – Thinking Out of The Box
January 2024
CME INDIA Case Study: A Curious Case of Hemoptysis – Thinking Out of The Box...

A Journey Through Interesting ECGs (Part-1)
January 2024
CME INDIA Case Study: A Journey Through Interesting ECGs (Part-1)...

A Journey Through Interesting ECGs (Part-2)
January 2024
CME INDIA Case Study: A Journey Through Interesting ECGs (Part-2)...

Dermatology is all about pictures and visuals: Diagnose the Challenge
January 2024
CME INDIA Case Study: Dermatology is all about pictures and visuals: Diagnose the Challenge...

Family with Les yeux fermés (Closed eyes)
January 2024
CME INDIA Case Study: Family with Les yeux fermés (Closed eyes)...

Post Insulin Injection Lesions in A Whorled Pattern – The Diagnostic Dilemma
January 2024
CME INDIA Case Study: Post Insulin Injection Lesions in A Whorled Pattern – The Diagnostic Dilemma...

Puzzle: 42-Yr.-Old Male Patient with Left Sided Chest Pain of 1 Day Duration
January 2024
CME INDIA Case Study: Puzzle: 42-Yr.-Old Male Patient with Left Sided Chest Pain of 1 Day Duration...

Recurrent Abdominal Pain and Elevated Triglycerides in a 15-year-old Diabetic Patient
January 2024
CME INDIA Case Study: Recurrent Abdominal Pain and Elevated Triglycerides in a 15-year-old Diabetic Patient...

Tetralogy of Fallot with Pulmonary Hyperemia
January 2024
CME INDIA Case Study: Tetralogy of Fallot with Pulmonary Hyperemia...
There is always a way; if there isn’t, make one! – IP (Interstitial Pulmonary diseases) beyond barriers
January 2024
CME INDIA Case Study: There is always a way; if there isn’t, make one! – IP (Interstitial Pulmonary diseases) beyond bar...

‘Two roads diverged in front of me. Good I took both and that made all the difference!’
January 2024
CME INDIA Case Study: ‘Two roads diverged in front of me. Good I took both and that made all the difference!’...